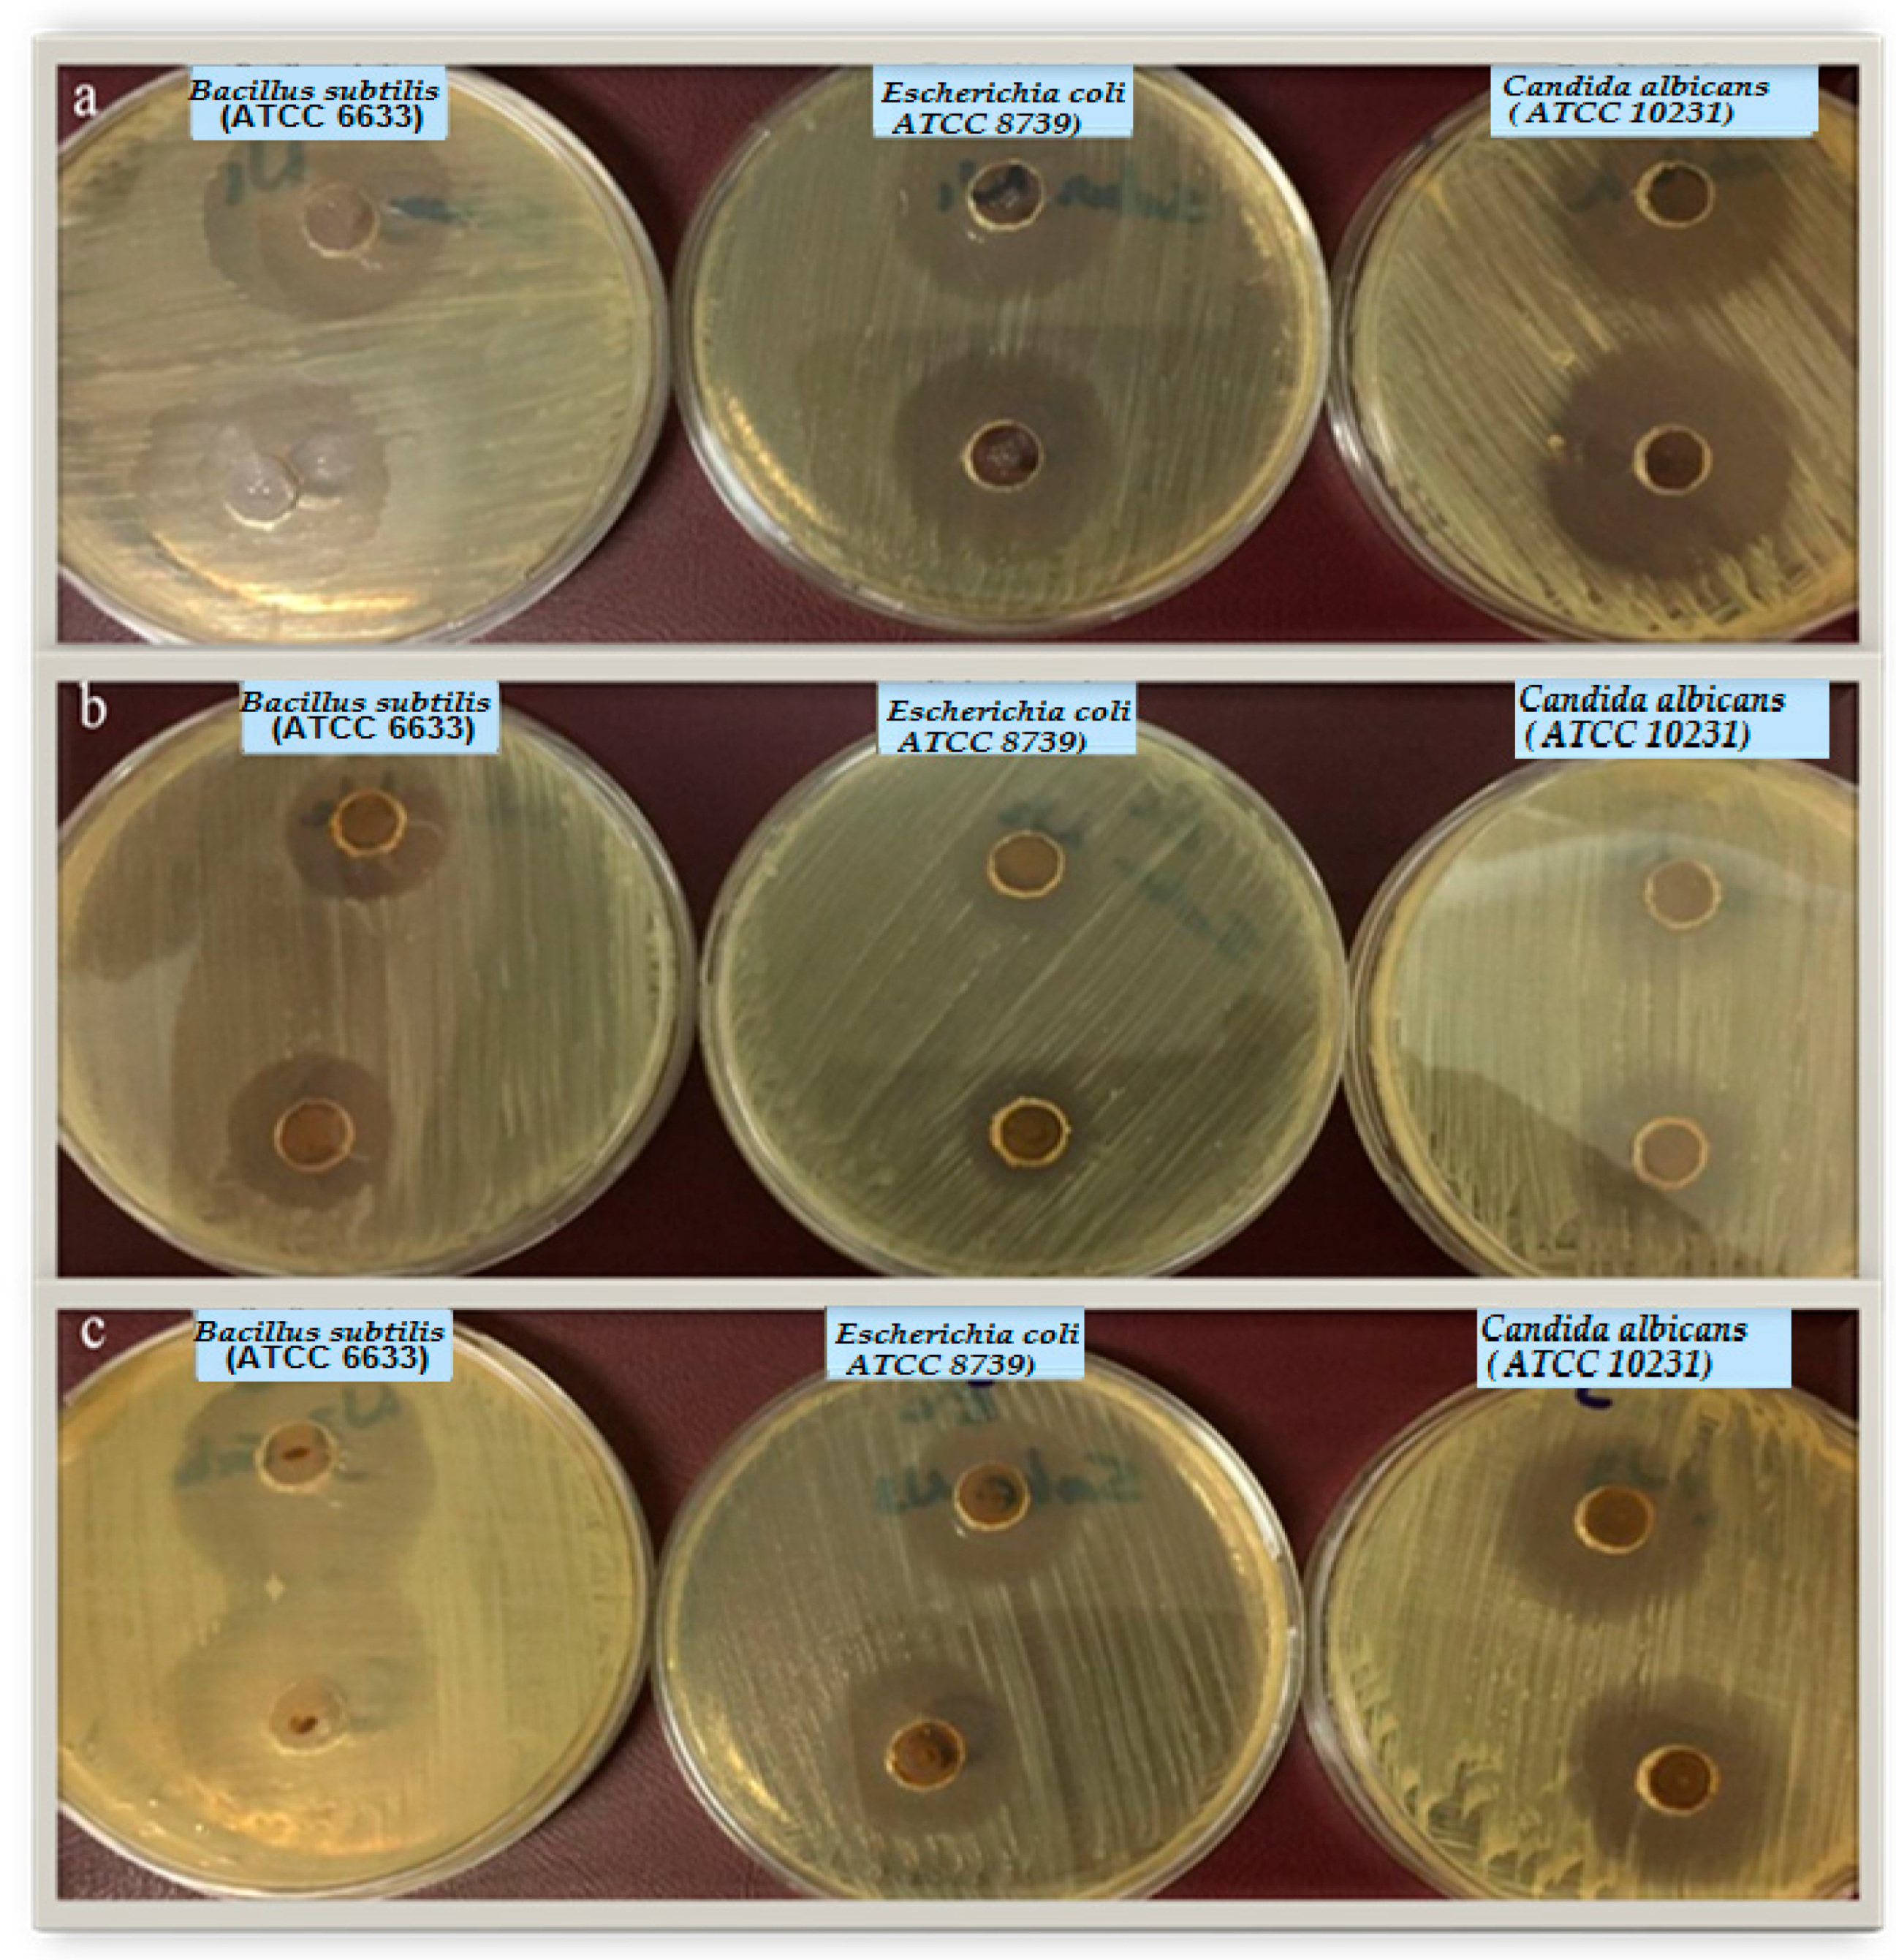
Materials 12 03604 g006

Antimicrobial Activity of Hybrids Terpolymers Based on Magnetite Hydrogel Nanocomposites
Abstract
:1. Introduction
2. Experimental
2.1. Materials
2.2. Techniques
Synthesis of Nanocomposite Hydrogel
2.3. Characterization
2.3.1. Swelling Behavior
2.3.2. Biological Activity
2.3.3. Minimum Inhibitory Concentration (MIC) and Minimum Bactericidal/Fungicidal Concentration (MBC/MFC) Measurement
3. Results and Discussion
3.1. Characterization of Polymer Composites
3.2. Swelling Curves
3.3. Biological Activity Results
4. Conclusions
Author Contributions
Funding
Acknowledgments
Conflicts of Interest
References
- Wei, L.; Hu, N.; Zhang, Y. Synthesis of polymer—Mesoporous silica nanocomposites. Materials 2010, 3, 4066–4079. [Google Scholar] [CrossRef] [PubMed]
- Datta, K.; Achari, A.; Eswaramoorthy, M. Aminoclay: A functional layered material with multifaceted applications. J. Mater. Chem. A 2013, 1, 6707–6718. [Google Scholar] [CrossRef]
- Janas, D.; Boncel, S.; Koziol, K.K. Electrothermal halogenation of carbon nanotube films. Carbon 2014, 73, 259–266. [Google Scholar] [CrossRef]
- Gaharwar, A.K.; Peppas, N.A.; Khademhosseini, A. Nanocomposite hydrogels for biomedical applications. Biotechnol. Bioeng. 2014, 111, 441–453. [Google Scholar] [CrossRef] [PubMed]
- Sharma, G.; Thakur, B.; Naushad, M.; Kumar, A.; Stadler, F.J.; Alfadul, S.M.; Mola, G.T. Applications of nanocomposite hydrogels for biomedical engineering and environmental protection. Environ. Chem. Lett. 2018, 16, 113–146. [Google Scholar] [CrossRef]
- Song, F.; Li, X.; Wang, Q.; Liao, L.; Zhang, C. Nanocomposite hydrogels and their applications in drug delivery and tissue engineering. J. Biomed. Nanotechnol. 2015, 11, 40–52. [Google Scholar] [CrossRef]
- Shin, M.K.; Spinks, G.M.; Shin, S.R.; Kim, S.I.; Kim, S.J. Nanocomposite hydrogel with high toughness for bioactuators. Adv. Mater. 2009, 21, 1712–1715. [Google Scholar] [CrossRef]
- Adhikari, B.; Biswas, A.; Banerjee, A. Graphene oxide-based hydrogels to make metal nanoparticle-containing reduced graphene oxide-based functional hybrid hydrogels. ACS Appl. Mater. Interfaces 2012, 4, 5472–5482. [Google Scholar] [CrossRef]
- Goenka, S.; Sant, V.; Sant, S. Graphene-based nanomaterials for drug delivery and tissue engineering. J. Control. Release 2014, 173, 75–88. [Google Scholar] [CrossRef]
- Tiwari, A.; Grailer, J.J.; Pilla, S.; Steeber, D.A.; Gong, S. Biodegradable hydrogels based on novel photopolymerizable guar gum–methacrylate macromonomers for in situ fabrication of tissue engineering scaffolds. Acta Biomater. 2009, 5, 3441–3452. [Google Scholar] [CrossRef]
- Madhumathi, K.; Kumar, P.S.; Abhilash, S.; Sreeja, V.; Tamura, H.; Manzoor, K.; Nair, S.; Jayakumar, R. Development of novel chitin/nanosilver composite scaffolds for wound dressing applications. J. Mater. Sci. Mater. Med. 2010, 21, 807–813. [Google Scholar] [CrossRef] [PubMed]
- Eid, M.; El-Arnaouty, M.; Salah, M.; Soliman, E.-S.; Hegazy, E.-S.A. Radiation synthesis and characterization of poly (vinyl alcohol)/poly (N-vinyl-2-pyrrolidone) based hydrogels containing silver nanoparticles. J. Polym. Res. 2012, 19, 9835. [Google Scholar] [CrossRef]
- Varaprasad, K.; Raghavendra, G.M.; Jayaramudu, T.; Yallapu, M.M.; Sadiku, R. A mini review on hydrogels classification and recent developments in miscellaneous applications. Mater. Sci. Eng. C 2017, 79, 958–971. [Google Scholar] [CrossRef] [PubMed]
- Mohan, Y.M.; Lee, K.; Premkumar, T.; Geckeler, K.E. Hydrogel networks as nanoreactors: A novel approach to silver nanoparticles for antibacterial applications. Polymer 2007, 48, 158–164. [Google Scholar] [CrossRef]
- Tomar, A.; Garg, G. Short review on application of gold nanoparticles. Glob. J. Pharmacol. 2013, 7, 34–38. [Google Scholar]
- Campbell, J.L.; Arora, J.; Cowell, S.F. Quasi-cubic magnetite/silica core-shell nanoparticles as enhanced Mri contrast agents for cancer imaging. PLoS ONE 2011, 6, e21857. [Google Scholar] [CrossRef]
- Eyvazzadeh, N.; Shakeri-Zadeh, A.; Fekrazad, R. Gold-coated magnetic nanoparticle as a nanotheranostic agent for magnetic resonance imaging and photothermal therapy of cancer. Lasers Med. Sci. 2017, 32, 1469–1477. [Google Scholar] [CrossRef]
- Pang, Y.; Wang, C.; Wang, J. Fe3o4@Ag magnetic nanoparticles for microRNA capture and duplex-specific nuclease signal amplification based SERS detection in cancer cells. Biosens. Bioelectron. 2016, 79, 574–580. [Google Scholar] [CrossRef]
- Heidaria, F.; Bahrololooma, M.E.; Vashaeeb, D.; Tayebicd, T. In situ preparation of iron oxide nanoparticles in naturalhydroxyapatite/chitosan matrix for bone tissue engineering application. Ceram. Int. 2015, 41, 3094–3100. [Google Scholar] [CrossRef]
- Iconaru, S.L.; Prodan, A.M.; Coustumer, P.L.; Predoi, D. Synthesis and antibacterial and antibiofilm activity of iron oxide glycerol nanoparticles obtained by coprecipitation method. J. Chem. 2013, 2013, 412079. [Google Scholar] [CrossRef]
- Behera, S.S.; Patra, J.K.; Pramanik, K.; Panda, N.; Thatoi, H. Characterization and evaluation of antibacterial activities of chemically synthesized iron oxide nanoparticles. World J. Nano Sci. Eng. 2012, 2, 196–200. [Google Scholar] [CrossRef]
- Harifi, T.; Montazer, M. In situ synthesis of iron oxide nanoparticles on polyester fabric utilizing color, magnetic, antibacterial and sono-Fenton catalytic properties. J. Mater. Chem. B 2014, 2, 272–282. [Google Scholar] [CrossRef]
- Konwar, A.; Kalita, S.; Kotoky, J.; Chowdhury, D. Chitosan–iron oxide coated graphene oxide nanocomposite hydrogel: A robust and soft antimicrobial biofilm. ACS Appl. Mater. Interfaces 2016, 832, 20625–20634. [Google Scholar] [CrossRef] [PubMed]
- Akl, Z.F.; El-Saeed, S.M.; Atta, A.M. In-situ synthesis of magnetite acrylamide amino-amidoxime nanocomposite adsorbent for highly efficient sorption of U (VI) ions. J. Ind. Eng. Chem. 2016, 34, 105–116. [Google Scholar] [CrossRef]
- Atta, A.M.; Gafer, A.K.; Al-Lohedan, H.A.; Abdullah, M.M.S.; Ezzat, A.O. Preparation of magnetite and silver poly(2-acrylamido-2-methyl propane sulfonic acid-co-acrylamide) nanocomposites for adsorption and catalytic degradation of methylene blue water pollutant. Polym. Int. 2019, 68, 1146–1177. [Google Scholar] [CrossRef]
- Al-Hussain, S.A.; Ezzat, A.O.; Gaffer, A.K.; Atta, A.M. Removal of organic water pollutant using magnetite nanomaterials embedded with ionic copolymers of 2-acrylamido-2-methylpropane sodium sulfonate cryogels. Polym. Int. 2018, 67, 166–177. [Google Scholar] [CrossRef]
- Bal, A.; Çepni, F.; Çakir, Ö.; Acar, I.; Güçlü, G. Synthesis and characterization of copolymeric and terpolymeric hydrogel-silver nanocomposites based on acrylic acid, acrylamide and itaconic acid: Investigation of their antibacterial activity against gram-negative bacteria. Braz. J. Chem. Eng. 2015, 32, 509–518. [Google Scholar] [CrossRef]
- Qavi, S.; Pourmahdian, S.; Eslami, H. Acrylamide hydrogels preparation via free radical crosslinking copolymerization: Kinetic study and morphological investigation. J. Macromol. Sci. Part A 2014, 51, 842–848. [Google Scholar] [CrossRef]
- Balouiri, M.; Sadiki, M.; Ibnsouda, S.K. Methods for in vitro evaluating antimicrobial activity: A review. J. Pharm. Anal. 2016, 6, 71–79. [Google Scholar] [CrossRef]
- Labena, A.; Kabel, K.; Farag, R. One-pot synthesize of dendritic hyperbranched PAMAM and assessment as a broad spectrum antimicrobial agent and anti-biofilm. Mater. Sci. Eng. C 2016, 58, 1150–1159. [Google Scholar] [CrossRef]
- Wiegand, I.; Hilpert, K.; Hancock, R.E. Agar and broth dilution methods to determine the minimal inhibitory concentration (MIC) of antimicrobial substances. Nat. Protoc. 2008, 3, 163. [Google Scholar] [CrossRef] [PubMed]
- Modrow, S.; Falke, D.; Truyen, U.; Schätzl, H. Molecular Virology; Springer: Berlin/Heidelberg, Germany, 2013. [Google Scholar]
- Amsterdam, D. Susceptibility testing of antimicrobials in liquid media. Antibiot. Lab. Med. 1996, 4, 61–143. [Google Scholar]
- Clinical and Laboratory Standards Institute. Methods for dilution antimicrobial susceptibility tests for bacteria that grow aerobically. Approv. Stand. 2006, 26, 14–16. [Google Scholar]
- Rukayadi, Y.; Han, S.; Yong, D.; Hwang, J.-K. In vitro antibacterial activity of panduratin A against enterococci clinical isolates. Biol. Pharm. Bull. 2010, 33, 1489–1493. [Google Scholar] [CrossRef] [PubMed]
- Kebbekus, B.B. Introduction to Organic Spectroscopy; Harwood, L.M., Claridge, T.D.W., Eds.; Oxford University Press: Oxford, UK, 1997; ISBN 0-19-855755-8. [Google Scholar]
- Kim, H.C.; Gao, X.; Jayaramudu, T.; Kang, J.; Kim, J. Optical and electro-active properties of polyacrylamide/CNC composite hydrogels. Mater. Sci. 2017, 34, 575–580. [Google Scholar] [CrossRef]
- Nakamura, T.; Tamura, A.; Murotani, H.; Oishi, M.; Jinji, Y.; Matsuishi, K.; Nagasaki, Y. Large payloads of gold nanoparticles into the polyamine network core of stimuli-responsive PEGylated nanogels for selective and noninvasive cancer photothermal therapy. Nanoscale 2010, 2, 739–746. [Google Scholar] [CrossRef] [PubMed]
- Bajai, P.; Paliwal, D.K.; Gupta, A.K. Acrylonitrile-acrylic acids copolymers. 1. synthesis and characterization. J. Appl. Polym. Sci. 1993, 49, 823–833. [Google Scholar] [CrossRef]
- Chapiro, A. Influence of solvents on apparent reactivity ratios in the free radical copolymerization of polar monomers. Eur. Polym. J. 1989, 25, 713–717. [Google Scholar] [CrossRef]
- Farag, R.; Mohamed, R. Synthesis and characterization of carboxymethyl chitosan nanogels for swelling studies and antimicrobial activity. Molecules 2012, 18, 190–203. [Google Scholar] [CrossRef]
- Kenawy, E.-R.; Worley, S.; Broughton, R. The chemistry and applications of antimicrobial polymers: A state-of-the-art review. Biomacromolecules 2007, 8, 1359–1384. [Google Scholar] [CrossRef]
- Gratzl, G.; Paulik, C.; Hild, S.; Guggenbichler, J.P.; Lackner, M. Antimicrobial activity of poly (acrylic acid) block copolymers. Mater. Sci. Eng. C 2014, 38, 94–100. [Google Scholar] [CrossRef]
- Krulwich, T.A.; Sachs, G.; Padan, E. Molecular aspects of bacterial pH sensing and homeostasis. Nat. Rev. Microbiol. 2011, 9, 330. [Google Scholar] [CrossRef] [PubMed]
- Zollfrank, C.; Gutbrod, K.; Wechsler, P.; Guggenbichler, J.P. Antimicrobial activity of transition metal acid MoO3 prevents microbial growth on material surfaces. Mater. Sci. Eng. C 2012, 32, 47–54. [Google Scholar] [CrossRef] [PubMed]
- Foster, J.W. Escherichia coli acid resistance: Tales of an amateur acidophile. Nat. Rev. Microbiol. 2004, 2, 898. [Google Scholar] [CrossRef] [PubMed]
- Goddard, J.M.; Hotchkiss, J. Polymer surface modification for the attachment of bioactive compounds. Prog. Polym. Sci. 2007, 32, 698–725. [Google Scholar] [CrossRef]
- Matche, R.; Kulkarni, G.; Raj, B. Modification of ethylene acrylic acid film for antimicrobial activity. J. Appl. Polym. Sci. 2006, 100, 3063–3068. [Google Scholar] [CrossRef]
- Bassolé, I.H.N.; Juliani, H.R. Essential oils in combination and their antimicrobial properties. Molecules 2012, 17, 3989–4006. [Google Scholar] [CrossRef]
- Lang, G.; Buchbauer, G. A review on recent research results (2008–2010) on essential oils as antimicrobials and antifungals. A review. Flavour Fragr. J. 2012, 27, 13–39. [Google Scholar] [CrossRef]
- Edris, A.E. Pharmaceutical and therapeutic potentials of essential oils and their individual volatile constituents: A review. Phytother. Res. 2007, 21, 308–323. [Google Scholar] [CrossRef]
- Iemma, F.; Puoci, F.; Curcio, M.; Parisi, O.I.; Cirillo, G.; Spizzirri, U.G.; Picci, N. Ferulic acid as a comonomer in the synthesis of a novel polymeric chain with biological properties. J. Appl. Polym. Sci. 2010, 115, 784–789. [Google Scholar] [CrossRef]

| Sample Name | Monomers Recipe | |||||||
|---|---|---|---|---|---|---|---|---|
| AMPS (g) | AA (mL) | AN (mL) | AAm (g) | EDGMA (mL) | BP (g) | Fe3O4 (g) | Water mL | |
| N1 | 0.52 | 0.72 | 0.53 | - | 0.177 | 0.15 | 0.195 | 50 |
| N2 | 0.52 | 0.72 | 1.06 | - | 0.23 | 0.15 | 0.258 | 50 |
| N3 | 0.52 | 0.72 | 2.12 | - | 0.33 | 0.15 | 0.369 | 50 |
| C1 | 0.52 | 0.72 | 0.53 | - | 0.177 | 0.15 | - | 50 |
| X1 | - | 0.72 | 0.53 | 0.71 | 0.196 | 0.15 | 0.216 | 50 |
| X2 | - | 0.72 | 1.06 | 1.42 | 0.320 | 0.15 | 0.352 | 50 |
| X3 | - | 0.72 | 2.12 | 2.84 | 0.568 | 0.15 | 0.625 | 50 |
| C2 | - | 0.72 | 0.53 | 0.71 | 0.196 | 0.15 | - | 50 |
| Samples | Bacillus subtilis | Escherichia coli | Candida albicans |
|---|---|---|---|
| Inhibition Zone (mm) | |||
| X1 | 32.6 ± 0.4 | 29.0 ± 1.0 | 29.0 ± 1.0 |
| X2 | 23.5 ± 0.5 | 19.3 ± 0.9 | 21.5 ± 1.5 |
| X3 | 36.0 ± 0.0 | 25.3 ± 0.4 | 26.5 ± 0.5 |
| * AMC (100 ppm) | 18 | ||
| * TE (100 ppm) | 22 | ||
| * Flu (100 ppm) | 17 | ||
| Samples | Bacillus subtilis | Escherichia coli | Candida albicans | |||
|---|---|---|---|---|---|---|
| MIC (PPM) | MBC (PPM) | MIC (PPM) | MBC (PPM) | MIC (PPM) | MFC (PPM) | |
| X1 MAGNETITE/TERPOLYMER HYBRIDE MAGNETITE/TERPOLYMER HYBRID | 15.62 | 62.5 | 31.2 | 125 | 15.6 | 31.2 |
| X2 | 125 | 250 | 125 | 500 | 62.5 | 125 |
| X3 | 62.5 | 125 | 62.5 | 250 | 31.2 | 62.5 |
© 2019 by the authors. Licensee MDPI, Basel, Switzerland. This article is an open access article distributed under the terms and conditions of the Creative Commons Attribution (CC BY) license (http://creativecommons.org/licenses/by/4.0/).
Share and Cite
Farag, R.K.; Labena, A.; Fakhry, S.H.; Safwat, G.; Diab, A.; Atta, A.M. Antimicrobial Activity of Hybrids Terpolymers Based on Magnetite Hydrogel Nanocomposites. Materials 2019, 12, 3604. https://doi.org/10.3390/ma12213604
Farag RK, Labena A, Fakhry SH, Safwat G, Diab A, Atta AM. Antimicrobial Activity of Hybrids Terpolymers Based on Magnetite Hydrogel Nanocomposites. Materials. 2019; 12(21):3604. https://doi.org/10.3390/ma12213604
Chicago/Turabian StyleFarag, Reem K., Ahmed Labena, Sahar H. Fakhry, Gehan Safwat, Ayman Diab, and Ayman M. Atta. 2019. "Antimicrobial Activity of Hybrids Terpolymers Based on Magnetite Hydrogel Nanocomposites" Materials 12, no. 21: 3604. https://doi.org/10.3390/ma12213604
APA StyleFarag, R. K., Labena, A., Fakhry, S. H., Safwat, G., Diab, A., & Atta, A. M. (2019). Antimicrobial Activity of Hybrids Terpolymers Based on Magnetite Hydrogel Nanocomposites. Materials, 12(21), 3604. https://doi.org/10.3390/ma12213604

